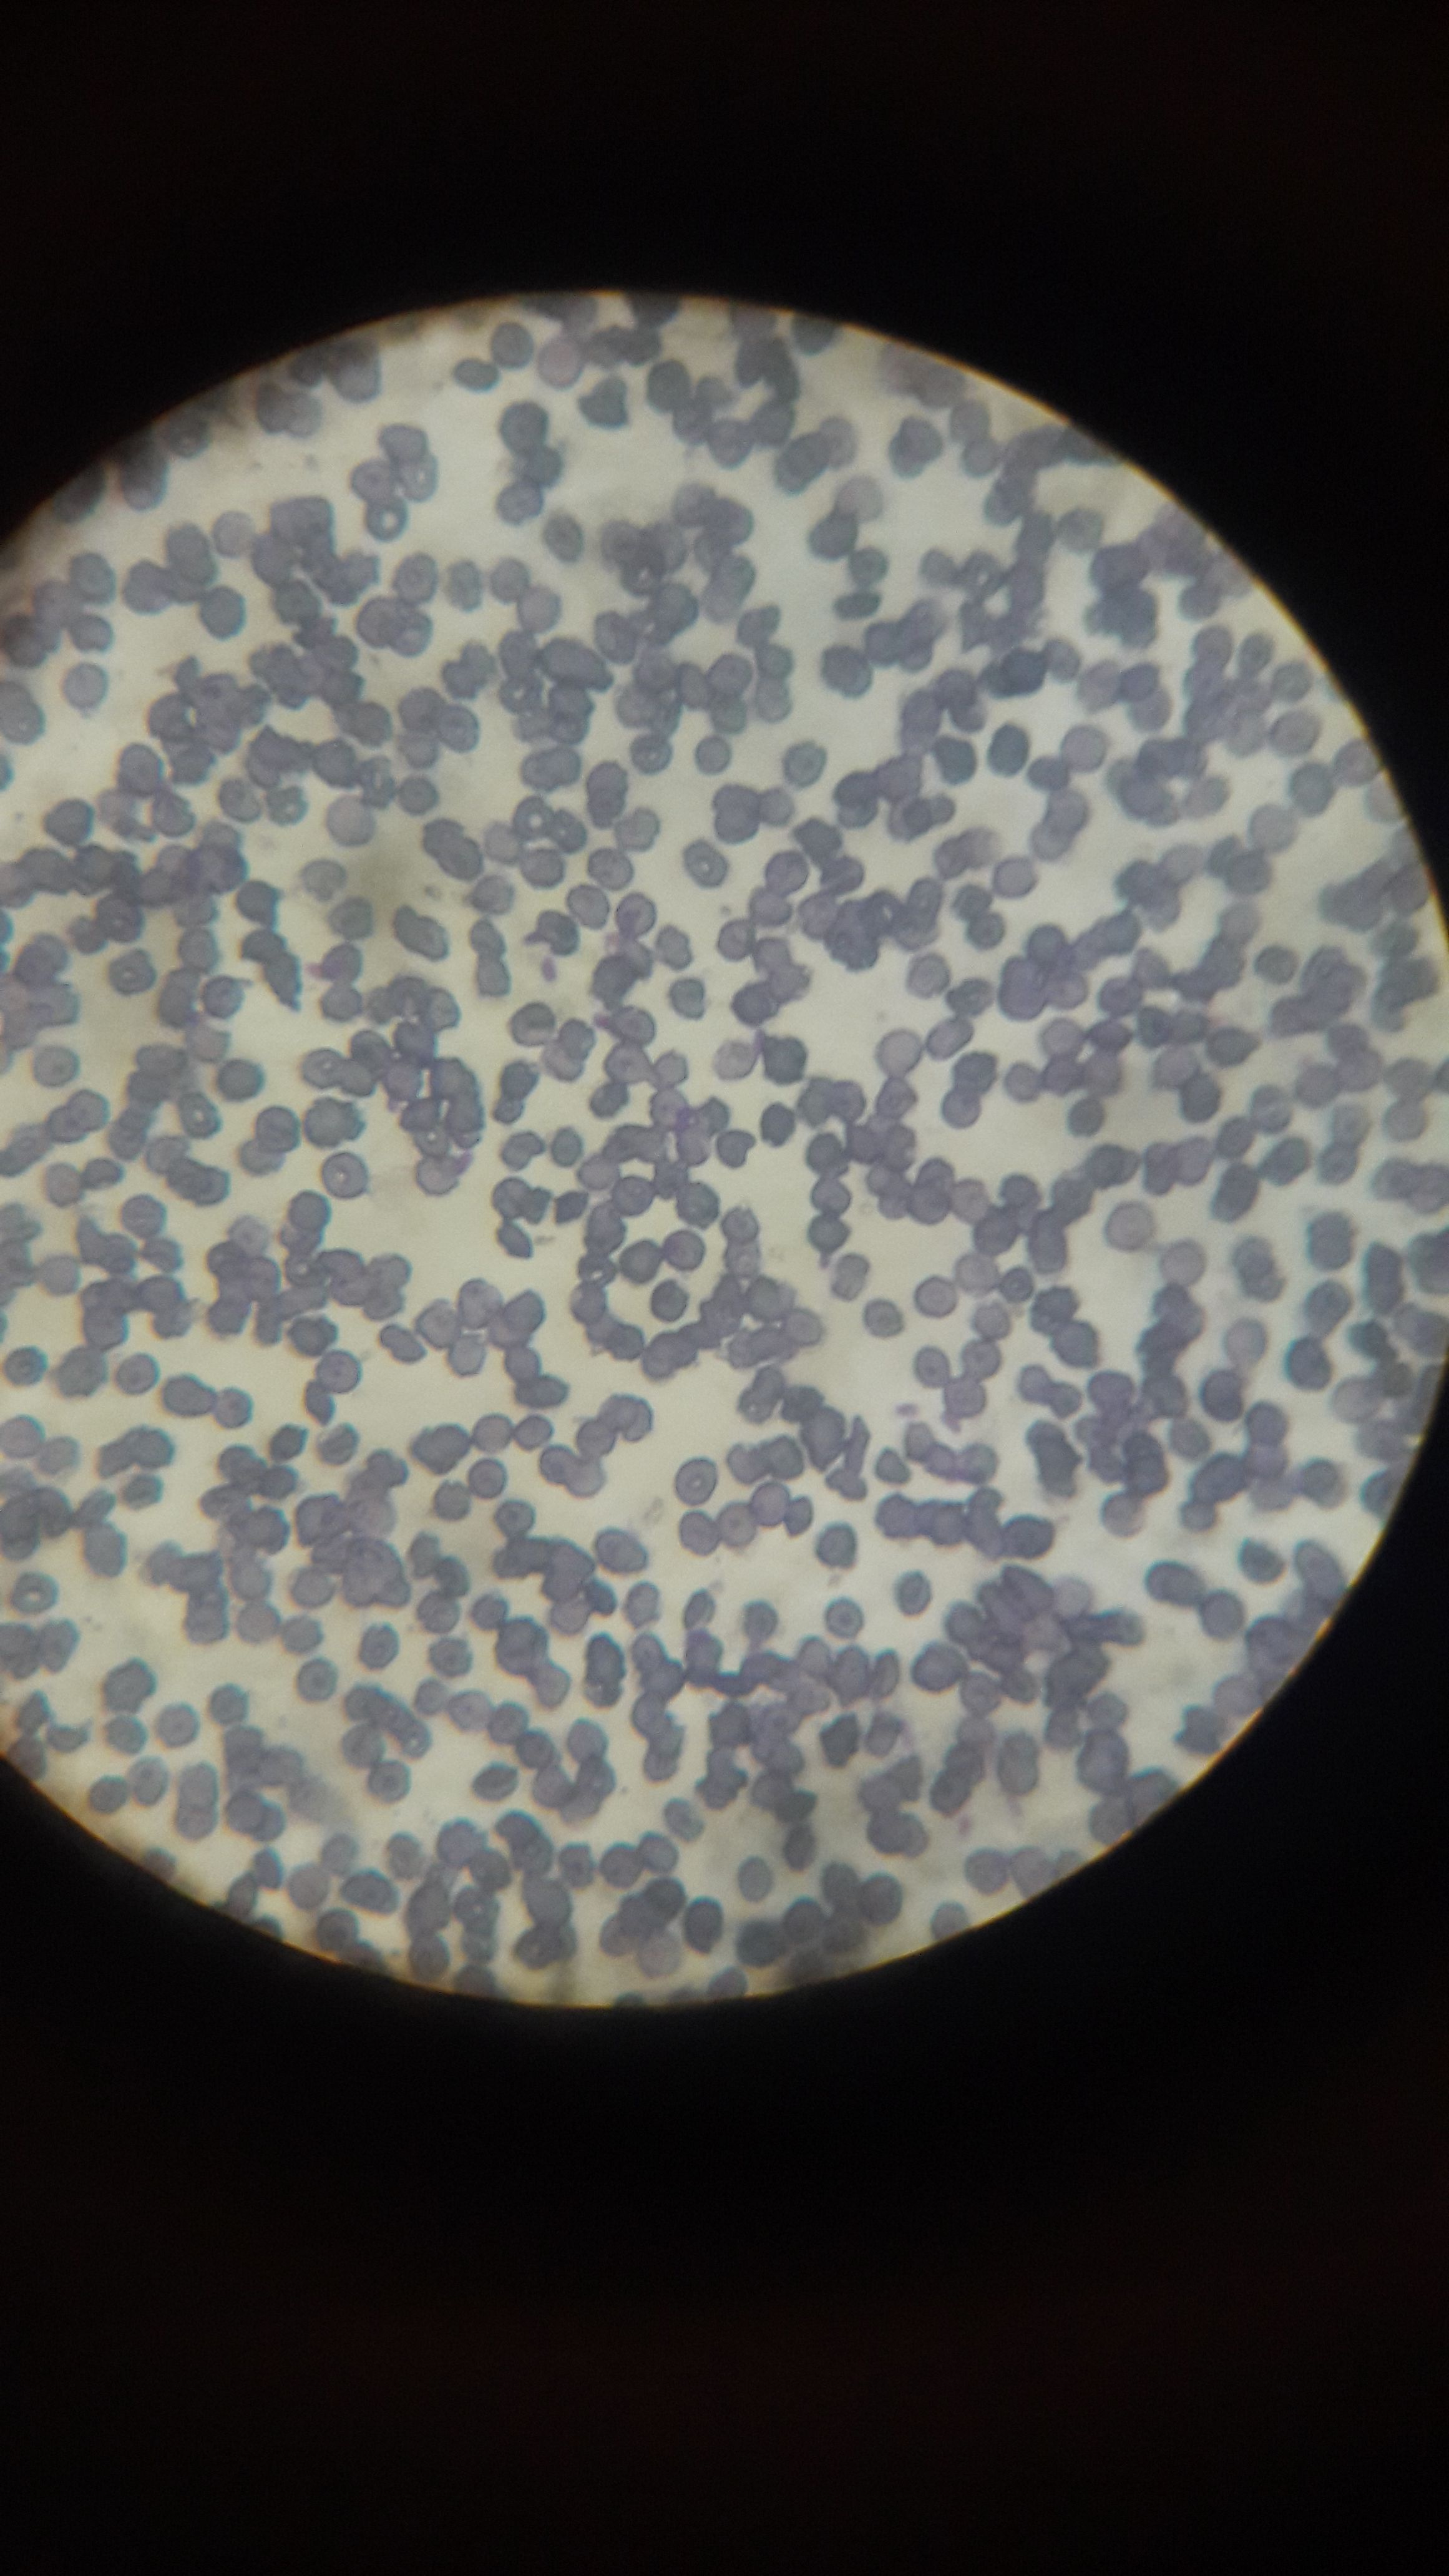

Ulog #011|| COLOR EVERYWHERE
"Colors are the smile of nature."
In my day to day work, I sometimes end up a little moody and intolerant of the hectic schedule. But my dad (Who is my mentor) taught me to always look for something that could inspire me to pursue and finish something that I started.
So today, I want to share with you the different #photographs I took inside my workplace. The color combination amuses me each day.

These are the micro tube we use for patients who are under 12 yrs old. (Kiddie tubes)

This is a stunning shot of the micro-pipette tips.

Micro-pipette tips together with the normal size pipette tips.
And lastly I was lucky enough to shot a HAPPY Red Blood Cells under the microscope hehehe
It's really good to see different colors anywhere we go. Color for me gives happiness and it lightens up the day which helps us be efficient in everything we do. Our God is indeed the greatest artist for creating the different astonishing color that we see day by day.
That would be all for today guys :-) Please support @surpassinggoogle with his #Ulog movement by creating your own version and by voting @steemgigs as your witness.
Keep Loving,
Maye